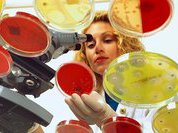

Архив за 07 апреля 2011
Почему микробы полюбили антибиотики?
 Профилактика
Профилактика
Профилактика
Профилактика
Во Всемирный день здоровья, который отмечается по традиции в ознаменование создания ВОЗ, организация констатирует: среди мировой "заразы" растет устойчивость к противомикробным препаратам. И если сегодня не принять меры, завтра мы останемся без лекарств. Что случилось?
"Кто не спрятался – я не виновата!" - сказала радиация
 Первая помощь
Первая помощь
 Первая помощь
Первая помощь
Каждый житель планеты Земля получает различные дозы радиоактивного излучения как от естественных источников, так и от искусственных. При долгом облучении или больших дозах радиация может разрушать клетки и стать причиной злокачественных новообразований и гибели организма. Как защититься от нее?

